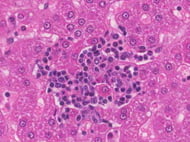
Rat Bone Marrow Derived Mononuclear Cells

Bone Marrow Derived Stem Cells
Bone marrow is recognized to be the chief and the most accessible stem cell source recently. The bone marrow niche is responsible for holding the heterogeneous population of mesenchymal stromal cells, along with cells of hematopoietic origin; in order to offer physical support to their hematopoietic counterparts and also differentiate into different progenitors to guarantee a functional remodeling of the BM niche. More importantly, these stromal cells are also involved in the direct regulation of hematopoietic homeostasis in a paracrine manner through the secretion of different soluble factors. Due to these specific properties, these cells have high demand currently for multiple in vivo, in vitro, and ex vivo assays. Kosheeka is providing cells with the optimum in-house quality control procedures.The cells are tested for morphological analysis, growth rate potential, adherence rate potential, and surface characterization potential for a comprehensive panel of markers. The cell sources are also assessed for infectious panel markers like HIV-1/2, HBV, HCV and HTLV 1/2, etc.
If you are looking for any specific products please feel free to fill the
CD 34 positive cells
Cat No: #0205HU00Human Bone Marrow-Derived CD 34 positive cells are a subpopulation of hematopoietic stem cells, present in the niche. The differentiation potential of these cells is highly investigated forming...
Dendritic cells
Cat No: #0208HU00Dendritic cells act as immune messengers and are primarily involved in processing antigens derived from pathogens. The dendritic cells are also responsible for presenting these pathogens to T...
Mesenchymal Stem Cells
Cat No: #0201HU00Mesenchymal stem cells, also commonly known as mesenchymal stromal cells obtained from bone marrow are multipotent cells with the ability to differentiate into cells of various mesenchyme origins....
Mononuclear cells
Cat No: #0206HU00The Human Bone Marrow-Derived mononuclear cells are a mixed population of precursor cells with a single nucleus. The fraction includes monocytes, lymphocytes, as well as hematopoietic stem and...
NK Cells
Cat No: #0207HU00The natural killer cells, also commonly known as the NK cells are the lymphocytes or the fighter cells of the immune system; which are primarily recruited by the...
Dendritic Cells
Cat No: #0208MS01Dendritic Cells are “tree-shaped” Bone-marrow derived Leukocytes responsible for initiation of adaptive immune responses. They are the most potent antigen-presenting cells. Since they induce T Cell activation research...
Mesenchymal Stem Cells
Cat No: #0201MS01Mesenchymal Stem Cells derived from adipose tissue have immense regenrative potential. They are responsible for replacing damaged tissue and maintaining an extracellular matrix. They are used for toxiticity...
NK Cells C57
Cat No: #0207MS01Natural Killer Cells commonly referred to as NK Cells are a type of innate lymphocyte which aid the immune system by killing virally infected cells and controlling signs...
NK Cells CD1
Cat No: #0207MS01Natural Killer Cells commonly referred to as NK Cells are a type of innate lymphocyte which aid the immune system by killing virally infected cells and controlling signs...
Dendritic Cells-Immuno-deficient
Cat No: #0208RA03Dendritic Cells are “tree-shaped” Bone-marrow derived Leukocytes responsible for initiation of adaptive immune responses. They are the most potent antigen-presenting cells. Since they induce T Cell activation research...
Dendritic Cells -SD
Cat No: #0208RA01Dendritic Cells are “tree-shaped” Bone-marrow derived Leukocytes responsible for initiation of adaptive immune responses. They are the most potent antigen-presenting cells. Since they induce T Cell activation research...
Dendritic Cells-Wistar
Cat No: #0208RA02Dendritic Cells are “tree-shaped” Bone-marrow derived Leukocytes responsible for initiation of adaptive immune responses. They are the most potent antigen-presenting cells. Since they induce T Cell activation research...
Mesenchymal Stem Cells-Immuno-deficient
Cat No: #0201RA03Mesenchymal Stem Cells derived from adipose tissue have immense regenrative potential. They are responsible for replacing damaged tissue and maintaining an extracellular matrix. They are used for toxiticity...
Mesenchymal Stem Cells-SD
Cat No: #0201RA01Mesenchymal Stem Cells derived from adipose tissue have immense regenrative potential. They are responsible for replacing damaged tissue and maintaining an extracellular matrix. They are used for toxiticity...
Mesenchymal Stem Cells-Wistar
Cat No: #0201RA02Mesenchymal Stem Cells derived from adipose tissue have immense regenerative potential. They are responsible for replacing damaged tissue and maintaining an extracellular matrix. They are used for toxicity...
Mononuclear Cells-SD
Cat No: #0206RA01Rat Bone Marrow Derived Mononuclear cells isolated from bone marrow, referes to a mixed population of cells that show regenrative and immunomodulatory potential. They are used in various...
Mononuclear Cells-Immuno-deficient
Cat No: #0206RA03Mononuclear cells isolated from bone marrow, referes to a mixed population of cells that show regenrative and immunomodulatory potential. They are used in various in vitro assays and...
Mononuclear Cells-Wistar
Cat No: #0206RA02Rat Bone Marrow Derived Mononuclear cells isolated from bone marrow, refers to a mixed population of cells that show regenerative and immunomodulatory potential. They are used in various...
Muse Cells
Cat No: #Multi-lineage differentiating stress enduring cell (MUSE Cell) is a subpopulation of Bone-marrow MSC’s. Unlike other types of stem cells hey are able to differentiate into all three germ...
NK Cells -Immuno-deficient
Cat No: #0207RA03Natural Killer Cells commonly referred to as NK Cells are a type of innate lymphocyte which aid the immune system by killing virally infected cells and controlling signs...
NK Cells -Wistar
Cat No: #0207RA02Natural Killer Cells commonly referred to as NK Cells are a type of innate lymphocyte which aid the immune system by killing virally infected cells and controlling signs...
Bone Marrow Mononuclear Cells
Cat No: #1406SW00Satellite cells are primary stem cells isolated from the porcine skeletal muscles. They can be differentiated from other cells due to the presence of paired box 7 (PAX-7)....
Primary Bone Osteoblasts
Cat No: #1406SW00Satellite cells are primary stem cells isolated from the porcine skeletal muscles. They can be differentiated from other cells due to the presence of paired box 7 (PAX-7)....
Primary Bone Osteoblasts
Cat No: #1406SW00Satellite cells are primary stem cells isolated from the porcine skeletal muscles. They can be differentiated from other cells due to the presence of paired box 7 (PAX-7)....